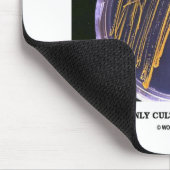
サポート細菌は何人かの人々しか培養しません頻繁に マウスパッド (コーナー)

マウスパッドについて
販売:
このデザインについて
サポート細菌は何人かの人々しか培養しません頻繁に マウスパッド
細菌のコロニーが付いている寒天培地が含まれているのこれらの冗談の科学的なことわざ楽しむbacteriologist、細菌学者、または生物学者がある必要性無し。 発言はそれをすべて言います: "サポート細菌-のは頻繁に何人かの人々"ある唯一の文化です。 他をこれらの文化に関してギフトを言う二重entendreのユーモアの何れかと驚いて見直させます!
自動翻訳
カスタマーレビュー
5つ星評価のうち星4.5全レビュー数 15
レビュー:15
類似商品のレビュー
5つ星評価のうち星5
砂田けい2020年4月17日 • 認証済みのご注文
マウスパッド
クリエイターレビュー
僕はマウスパット自体は何枚か作ってまして少し大きめが凄く使いやすくマウスの動きも凄く良い商品☆手触りも最高に良い☆
で、今回、自分的テストでこの『令和 Since May 1, 2019』バージョンを作成してみたところ☆
めっちゃめっちゃ最高に良い出来上がり☆ブラックに凄く渋いゴールドの文字っ☆
めっちゃ渋い感じで大人のムードが漂ってる雰囲気を醸し出している☆
実際の商品の文字の色合いが最高に良いっ☆ マウスパットとしても最高に使い勝手が良いっ☆
このサイトのこの商品の見た目よりも実物が最高に良いって思いました。
皆々様に最高にお勧めできる商品だと思いました。 印刷に関しても満足な出来上がり☆ ブラックの色合いも実物の方が良い。
『令和 Since May 1, 2019』のゴールドの文字も凄く渋い感じの落ち着いた色合いのゴールドであり。
大人のムードを漂わせるステキなマウスパットだと思った。
自画自賛のレビューになってしまってるが僕の本音で実物が凄く良いって思ったもので。
5つ星評価のうち星5
砂田けい2020年10月18日 • 認証済みのご注文
マウスパッド
クリエイターレビュー
この商品は、別バージョンで四つ?だったか作って使用してます。
大きさも納得いく使いやすい大きさです。大きめな所が良いです。マウスも凄く良い感じで使えます。
厚みも最初は分厚すぎるかな?と思ってましたがほぼパーフェクトベストな厚みです。
手触りも凄く良いです。僕自身別の場所で別バージョンを使ってますが。高級感もあり大変に使いやすく家族及び中の良い方とかにもプレゼントをして喜ばれてます。
この商品、プレゼントした方からも『凄く良い』っていう評価を頂いてます。
当方は自分でデザインできますので、また今使ってるのが汚れたりしたらまたこちらで作るつもりです。満足な一品です。 この令和バージョンの黒ですが。作ってはみたものの色がブラックとゴールドですので色写りとかあるかも?って思いながら試しに注文してみましたが実物が来て色合いも凄く良く。色写り等もないようです。
ちゃんと印刷が上手にできてるんだなって思いました。
思わず僕は従兄弟にも同じブラックに令和のゴールド文字をプレゼントしましたが喜んで頂けました。
印刷自体も全然問題なく良い出来だと思います。
5つ星評価のうち星5
Akira S.2018年7月4日 • 認証済みのご注文
マウスパッド
クリエイターレビュー
ひらがなとカタカナを対比させて、日本語の五十音を確認する事ができるので、日本語の勉強をしている人にはとても便利。しかも、デザイン的にもクールでスタイリッシュ。 小さな文字のディテールもクッキリ印刷されており、カスレやボケなどもなく視認性も高かったです。
タグ
その他の情報
商品 ID: 144272319979600189
出品日: 2010/9/8 20:05
レーティング: G
最近閲覧された商品